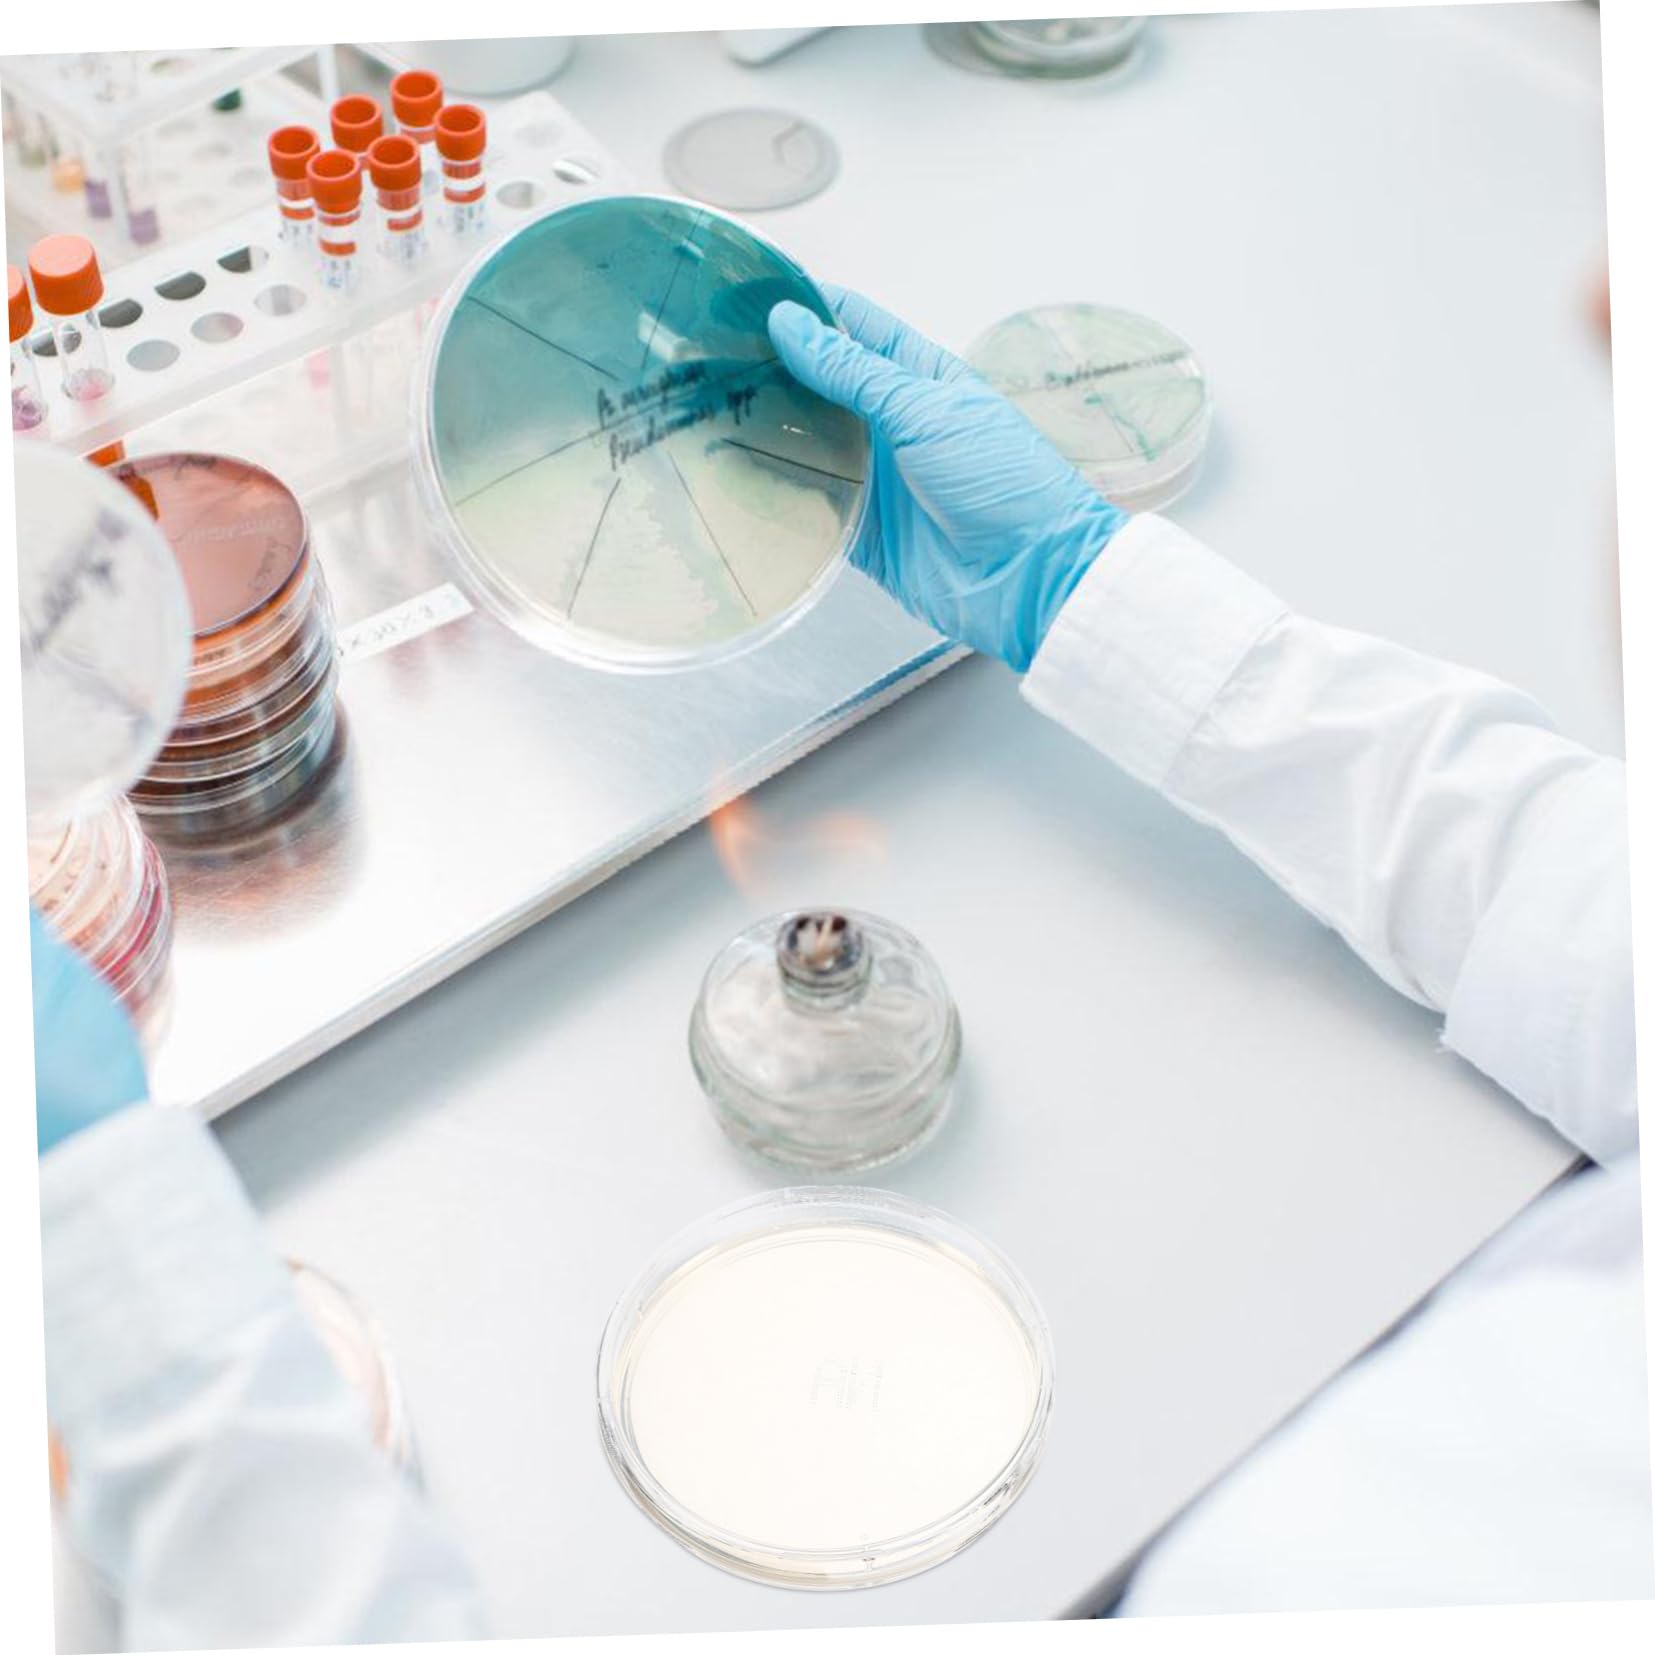
FUNOMOCYA 10pcs Agar Plate Experiment Supplies Science Projects Tool Laboratory Supplies Prepoured Petri Dish Agar Petri Dishes Agar Petri Plates Petri Dishes with Agar

Product Information
Specification
Brand : FUNOMOCYA
BulletPoint1 : Science experiment plates-- these agar plates are for culture storage, isolation of pure cultures, or general culture purposes, a versatile tool for any science experiment,prepoured agar petri dishes
BulletPoint2 : Agar plate-- compact and lightweight design of these petri plates makes them easy to use and transport, convenient tool for any science experiment,science projects tool
BulletPoint3 : Laboratory experiment supplies-- these agar plates are ideal for young students learning science, technology, engineering, and mathematics,lab agar plate
BulletPoint4 : Prepoured agar plates-- these petri plates are suitable for a wide range of , including medical, , scientific research, and laboratory analysis,petri dishes
BulletPoint5 : Agar petri dishes-- our agar plates are highly practical and easy to use, providing a great user experience for anyone conducting science experiments,petri dish
Color : As Shown
ExternallyAssignedProductIdentifier : 6976403642335
IncludedComponents : 1.
ItemDisplayDimensions_Length : 3.54 centimeters
ItemDisplayWeight : 0.73 pounds
ItemName : FUNOMOCYA 10pcs Agar Plate Experiment Supplies Science Projects Tool Laboratory Supplies Prepoured Petri Dish Agar Petri Dishes Agar Petri Plates Petri Dishes with Agar
ItemPackageDimensions_Height : 3.54 inches
ItemPackageDimensions_Length : 5.71 inches
ItemPackageDimensions_Width : 3.54 inches
ItemTypeKeyword : science-lab-petri-dishes
ItemVolume : 1 cubic_centimeters
Manufacturer : FUNOMOCYA
Material : agar
ModelNumber : W7H019GC509IGNBY374VH1J
NumberOfBoxes : 1
NumberOfItems : 1
NumberOfLithiumMetalCells : 1
PartNumber : W7H019GC509IGNBY374VH1J
ProductDescription : Package List
10 x Agar Plates
Characteristics
-Material:Agar experiment supplies
-Size:9.00X9.00X2.00cm/3.54X3.54X0.79in portable agar plate
-Color:As Shown agar plate
-Our agar plates are highly practical and easy to use, providing a great user experience for anyone conducting science experiments laboratory experiment supplies.
-These agar plates are for culture storage, isolation of pure cultures, or general culture purposes, a versatile tool for any science experiment prepoured agar plates.
-These agar plates are made from good workmanship that are designed to withstand long-term use, ensuring that they won't deform or break easily agar plates for experiment.
-Practical agar dishes are ideal for use in home experiments, classroom activities, and science projects, providing a reliable solution for your needs petri dishes with agar.
-These petri plates are suitable for a wide range of , including medical, , scientific research, and laboratory analysis agar plates for laboratory.
Goods Description
prepoured petri plates Our agar plates are designed to be portable and easy to use, making them for culture storage, isolation of pure cultures, or general culture in most science experiment occasions.petri dishes with agar They are made of detailed workmanship, ensuring their durability and reliability
ProductSiteLaunchDate : 2024-09-13T18:25:34.416Z
Size : 9.00X9.00X2.00CM
SupplierDeclaredDgHzRegulation : not_applicable
UnitCount : 1
UnspscCode : 41000000